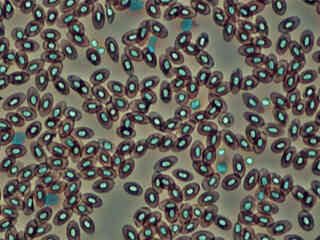
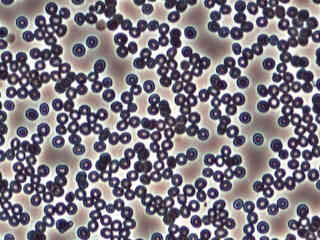

Phase Contrast
Transparent specimens often appear remarkably different when they are comparatively observed under positive and negative phase contrast illumination. In positive phase contrast, specimen intensity is manifested by relatively medium to dark gray features, surrounded by a bright halo, and superimposed on a lighter gray background. Alternatively, in negative phase contrast, the specimen often appears much brighter on a dark gray background and the accompanying halos are also dark (much darker than the background). This digital image gallery compares identical viewfields of a wide variety of specimens illuminated with both positive and negative phase contrast.